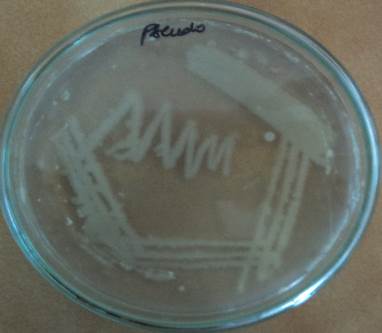

Department of Zoology, Thiruvalluvar University, Serkadu, Vellore, Tamil Nadu, India.
Email: sagoselvam@yahoo.co.in
Received: 07 Mar 2014 Revised and Accepted: 10 Apr 2014
ABSTRACT
Objective: The main objective was to evaluate the degradative properties of Pseudomonas aeruginosa sp TUHP1 isolated from TNT-Polluted soils in the Vellore District, Tamil Nadu, India.
Methods: Among the 3 bacterial genera isolated from different soil samples, one potent TNT degrading strain Pseudomonas aeruginosa sp TUHP1 was identified. The morphological, physiological and the biochemical properties of the strain Pseudomonas aeruginosa sp TUHP1 was confirmed by conventional methods and genotypic characterization was carried out using 16S r-DNA partial gene amplification and sequencing. The broken down by products of DNT in the extract was determined by Gas Chromatogram- Mass spectrometry (GC-MS). Supernatant samples from the broth studied at 24 h interval were analyzed by HPLC analysis and the effect on various nutritional and environmental factors were analysed and optimized for the isolate.
Results: Out of three isolates one strain TUHP1 were found to have potent efficiency to degrade TNT and revealed the genus Pseudomonas. 16S rDNA gene sequence analysis showed highest homology (99%) with Pseudomonas aeruginosa DS10 and was assigned as Pseudomonas aeruginosa sp TUHP1. Based on the energy of the predicted models, the secondary structure predicted by MFE showed the more stable structure with a minimum energy. Products of TNT Transformation showed colour change in the medium during cultivation. TNT derivates such as 2HADNT and 4HADNT were detected by HPLC chromatogram and 2ADNT, 4ADNT by GC/MS analysis.
Conclusion: Hence this study presents the clear evidence for the biodegradation process of TNT by strain Pseudomonas aeruginosa sp TUHP1.
Keywords: Bioremediation. Biodegradation. Biotransformation. Sequencing.
INTRODUCTION
Pollution due to chemicals including heavy metals is a problem that may have negative consequences on the biosphere. The most abundant pollutants in the wastewater and in sewage are heavy metals [16] with explosives, Moreover, accumulation of heavy metals in vegetation due to irrigation with waste water could affect human health [17]. Especially 2, 4, 6-trinitrotoluene (TNT), is a widespread problem at factories that produce explosive. The toxicity and mutagenecity of TNT can remain undecomposed for long periods as a solid or dissolved in groundwater which poses threats to the human health and environment [18].
The intake and subsequent efflux of heavy metal ions by microbes normally includes a redox reaction involving the metal. As such, some bacteria even use them for energy and growth [15]. Efforts have focused on developing methods to treat TNT biologically. A variety of ecosystems have been examined for microbes able to transform TNT as previously reported [12, 13, 14].One of the best methods to remove their toxicity from contaminated soil is known biological remediation with soil bacteria. Therefore, there are considerable efforts to use microorganisms for the biodegradation of TNT is the safe approach.
MATERIALS AND METHODS
Collection of polluted soil sample
Soil samples were collected from polluted soil in Vellore district, Tamilnadu, India. During the period of January (2013) at the depth of 5cm and processed for the analysis.
Isolation and identification of TNT degrading bacteria
One gram of soil sample per 100 mL of medium was added to minimal medium and cells grown aerobically with shaking (180 rpm) at 25 °C. Serial transfers (5 % inoculum) into fresh medium were made every 72 h. After three serial transfers, decolourised culture was transferred onto fresh agar plates
Screening and identification of TNT-metabolizing bacteria
TNT solution (100 mL) with M8 minimal medium containing TNT (100 mg/L) and acetate (10 mM) as nitrogen and carbon sources was mixed with 20 g of soil, and then the mixture was aerobically incubated at 27 °C in the dark with shaking (120 rpm). After 1-week incubation, serial dilutions were spread on M8 minimal medium agar plates with TNT and acetate. Colonies were isolated and characterized using standard procedures
Morphological and biochemical characterisation
The potent degrading isolate was further studied for it morphological including gram staining and biochemical observations including the colony size, color, shape, diameter, elevations, and whether opaque, transparent or translucent. The results were compared using Bergey's manual.
TNT biodegradation by isolated bacteria
Cells (about 5×106 cells/mL) were incubated in TNT solution (100 mL) with M8 minimal medium as production broth containing TNT (100 mg/L) and acetate (10 mM) at 30°C in the dark with shaking (120 rpm). Percentage biotransformation was calculated from the disappearance of TNT.
Cells were removed by centrifugation (5000×g, 10 min). The concentration of TNT was determined by measuring the absorbance at 447 nm of the supernatant (1.5 mL) supplemented with 240 μL 1 M NaOH26). Biodegradation of the aromatic ring of TNT was calculated from the disappearance of the aromatic ring as measured by absorbance at 230–280 nm. Nitrite was determined [8].
The absorbance was measured with a UV/VIS Spectrophotometer.
Identification of TNT metabolites
The cells were aerobically grown for different periods at 30°C and were removed by centrifugation at 5000rpm for 10 min. The culture fluid was extracted 3 times with 100 mL ethyl ether (pH 7.0) further the extracts were dried over anhydrous sodium sulfate, and excess solvent was removed by rotary evaporation under pressure at 30°C.
Gas Chromatography- Mass Spectrum Analysis
The Pseudomonas aeruginosa sp TUHP1 the culture fluid was subjected to GC-MS. The analysis was performed using GC SHIMADZU QP2010 system equipped with Elite-1 fused silica capillary column (Diameter: 0.25 mm, Length: 30.0 m, Film thickness: 0.25 μm. Helium gas (99.999%) was used as the carrier gas at a constant column flow rate of 1.51ml/min and an injection volume of 2μl, Ion-source temperature at 200°C and the ionization energy of 70eV with Injector temperature at 200°C. The oven temperature was at 70°C with an increase of 10 min at 300°C. Total GC running time was 35 min. Mass spectra were taken at 70eV; a scan interval of 0.5 seconds with scan range of 40 – 1000 m/z. NIST08 and WILEY8 database was used for the identification of the separated peaks. The relative percentage of each component was calculated by comparing its average peak area to the total areas [11].
HPLC analysis
TNT metabolites were identified by comparison of retention times and mass spectra between samples and standard chemicals were carried out by high performance liquid chromatography (HPLC). For HPLC analyses, 20 μL of elutions were injected into a C18 reverse-phase column at 30 °C and separated using an isocratic mobile phase of 21 % (vol/vol) acetonitrile, 35%methanol and 44%deionised water at a flow rate of 0.7 mL min−1. The retention time of TNT was determined by UV detector at 254 nm and quantified by comparison with reference standards. The HPLC method reported previously [6].
16S rDNA sequencing and analysis
Bacterial isolates were tested for species identity using the 16S rDNA sequencing method according to the methods of [19] To extract the bacterial genome. Colonies were picked up with a sterilized toothpick and suspended in 0.5 mL of sterilizes saline in a 1.5 mL centrifuge tube, centrifuged at 10,000 rpm for 10 min. After removal of supernatant, the pellet was suspended in 0.5 mL of Insta GeneMatrix(Bio-Rad, USA). Incubated at 56 oC for 30 min and then heated to 100oC for 10 min. After heating, supernatant can be used for PCR. Bacterial 16S rDNA were amplified by using the following universal bacterial primers: forward primer27 F (5’-AGAGTTTGATCMTGGCTCAG-3’) and reverse primer 1792 R (5’-TACGGYTACCTTGTTACGACTT-3’). Polymerase chain reaction was performed using kits with Ampli Taq DNA polymerase (FSenzyme) (Applied Biosystems). 1 μl of template DNA was added to 20 μl of PCR reaction solution. Amplification was performed using 35 cycles at 94°C for 45 sec, 55°C for 60 sec, and 72°C for 60 sec. Sequencing was performed using Big dye terminator cycle sequencing kit (Applied BioSystems, USA). Sequencing products were resolved on an Applied Biosystems model 3730XL automated DNA sequencing system (Applied BioSystems, USA). The sequences were subjected to homology search using BLAST programme of the National Center for Biotechnology Information (NCBI) [20].
The partial 16S rDNA sequences derived in this study have been deposited in Gen Bank under the accession number KC961638.
Molecular Characterization
Total genomic DNA was isolated using the phenol Chloroform method [1]. PCR amplification of 16S r-DNA was carried out using the primers FC27 (5_ to 3_ AGAGTTTGATCCTGGCTCAG) and RC1492 (5_to3_TACGGCTACCTTGTTACGACTT) [2]. The PCR product was detected by agarose gel electrophoresis. Sequencing was performed using big dye terminator cycle sequencing kit (Applied BioSystems, USA). The sequence was subjected to homology search using BLAST programme of the National Center for Biotechnology Information (NCBI) and the sequence data was submitted to the GenBank database under the accession number (KC961640).
Phylogenetic analysis
The acquired sequences was used for a gene homology search, with the 16S r-DNA sequences available in the public databases from BLAST and identified to the generic level [3, 4]. Using the CLUSTAL-X Multiple Sequence Alignment Program (Strasburg, France), the 16S r-DNA sequences of the strains were aligned with sequences of related organisms obtained from GenBank and a phylogenetic tree was constructed via the neighbor-joining method using the EvolView program [5]. To validate the reproducibility of the branching pattern, a bootstrap analysis was performed
RNA secondary structure prediction
The gene sequence was transcribed to RNA sequence to identify the rRNA secondary structure using the RNAfold server from Vienna RNA website [20]. RNA secondary structure can be predicted by free energy minimization with nearest neighbor parameters to evaluate stability [21]. It was used to predict the minimum free energy (MFE) secondary structure of single sequences using the dynamic programming algorithm proposed by Zuker and Stiegler [22] and equilibrium base-pairing probabilities were are calculated.
Growth curve
The potent Pseudomonas aeruginosa sp TUHP1 inoculated on production broth was subjected to growth curve analysis and biomass study. The readings were taken at an interval of 2h and were read at 610 nm using a colorimeter. The growth curves were plotted and the curves were used to determine the generation time, growth rate constant and mean generation time of the organism.
Optimization of process parameters
The effect of incubation period on production was studied by growing potent isolate Pseudomonas aeruginosa sp TUHP1 up to 24 h. The impact of pH and temperature was investigated by subjecting to various pH (6.0– 8.0) and temperature (4–55°C) settings. The optimum carbon utilization was determined by amending different sources into the medium at a concentration of 0.5% and nitrogen sources were supplemented as to study their influence on degradation.
Results and Discussion
A total of three organisms were isolated from soil sample of Vellore district, Tamilnadu, India. (Fig 1).
![]() |
![]() | ![]() |
![]() |
Fig. 1: Isolation of bacteria from soil contaminated with TNT
Out of three isolates one strain TUHP1 were found to have potent efficiency to tolerate TNT and to degrade (Table 1).
Table: 1 Degradation of TNT by strains isolated from soil sample from serkadu region, Vellore, Tamil Nadu, India.
| S. No. | Stains | TNT Degradation |
| 1 | TUHP1 | +++ |
| 2 | TUHP2 | + |
| 3 | TUHP3 | + |
For which the isolate TUHP1 was studied for its morphological and biochemical properties which revealed the genus Pseudomonas (Table 2).The pure culture plate is represented (Fig 2).
Table 2: Morphological & biochemical characterization of Pseudomonas aeruginosa sp TUHP1
| S. No. | Characterization | Pseudomonas aeruginosa sp TUHP1 |
| 1 | Grams Staining | Rod |
| 2 | Shape | 0.5-0.8x1.5-2.0 |
| 3 | Motility | + |
| 4 | Endospore formation | - |
| 5 | Catalase | + |
| 6 | Oxidase | + |
| 7 | Nitrate reductase | + |
| 8 | Casein | - |
| 9 | Starch | - |
| 10 | Urea | - |
| 11 | Gelatin | - |
| 12 | MR | + |
| 13 | VP | - |
| 14 | Indole | - |
| 15 | Gas production | - |
Colonies on nutrient agar
The morphological characterization of the isolates was found white colored colonies on nutrient agar. The microscopic observation upon gram staining strain was found to be gram negative rod shaped bacteia(Fig 3).
Fig. 2: Pure culture plate of Pseudomonas aeruginosa sp TUHP1

Fig. 3: Microscopic view (100X) of Gram stained Pseudomonas aeruginosa sp TUHP1
To confirm the identification of isolate TUHP1, 16S rDNA gene sequence analysis was performed. The sequence alignment using BLASTN software gave highest homology (99%) with Pseudomonas aeruginosa DS10 and was assigned with the strain name Pseudomonas aeruginosa sp TUHP1. A phylogenetic relationship was established through the alignment and cladistic analysis(Fig 4).

Fig. 4: 16S rDNA based phylogenetic tree showing the positions of all currently recognized Pseudomonas aeruginosa sp TUHP1 and some reference species of related genera. The tree was obtained using a neighbor-joining algorithm. Bootstrap values are based on 1000 runs and are shown where >50.

Fig. 5(a): RNA secondary structure,

Fig. 5(b): Base pair probabilities of Dot of the MFE structure plot

Fig. 5(c): Mountain plot representation
The secondary structure was predicted using RNAfold server (using MFE) with a minimum free energy of -319.12 kcal/mol. The centroid secondary structure was predicted with a minimum free energy of -231.60kcal/mol. Based on the energy of the predicted models, the secondary structure predicted by MFE showed the more stable structure with a minimum energy. Hence MFE model can be considered as the optimal secondary structure of the rRNA(Fig 5).
Mountain plot is also derived from RNAfold server which represents a secondary structure in a plot of height versus position, where the height is given by the number of base pairs enclosing the base at position i.e. loops correspond to plateaus (hairpin loops are peaks), helices to slopes. The capability of Pseudomonas to tolerate TNT was evaluated by its growth in degradation medium. Products of TNT Transformation showed colour change in the medium during cultivation. Colour of medium was whitish in the beginning and started turning yellowish finally with reddish brown coloration at 96 h (Fig 6).
![]() |
![]() |
![]() |
| A | B | C |
Fig. 6: Degradation of TNT after 24 h interval by Pseudomonas aeruginosa sp TUHP1

Fig. 7: HPLC chromatogram of culture filtrate of Pseudomonas aeruginosa sp TUHP1
The Pseudomonas aeruginosa sp TUHP1 studied for its generation time showed the lag phase with short duration and exponentially prolonged. This growth was followed by the stationary phase (up to 23 hours) and decline phase (after 30 hours) (Fig 9).

Fig. 8: Hydrolysed products of TNT degraded by Pseudomonas aeruginosa sp TUHP1

Fig. 9: Growth curve of Pseudomonas aeruginosa sp TUHP1

Fig. 10: Optimization of (A) carbon (B) nitrogen (C) aminoacids (D) pH; (E) temperature for the isolate Pseudomonas aeruginosa sp TUHP1
TNT derivates isolated from this reddish– brown-coloured supernatant were identified by GC-MS and HPLC analysis. 2HADNT and 4HADNT were detected by HPLC chromatogram (Fig 7). GC/MS analysis identified 2ADNT, 4ADNT as the metabolites from TNT(Fig 8).
The optimisation parameters have been found to favor the multiplication of the cells. The maximum biomass was obtained at 27oC at the pH at 7 with the maximum utilization of dextrose as suitable carbon source and yeast extract as better nitrogen source (Fig 10).
Most previous studies on TNT biodegradation addressed the treatment of TNT contaminated soils [7, 9, 10]. Hence in conclusion, Pseudomonas aeruginosa sp TUHP1 isolated from soil sample is a good candidate for the biodegradation of TNT by the reduction of its metabolites.
CONCLUSION
Recently, Biodegradation have been receiving attention because of their possible application for biotechnological applications as it is biodegradable with various applications in the environmental, agriculture. Hence it is observed that Pseudomonas aeruginosa sp TUHP1 degraded TNT from contaminated soil and the study is unique when compared to previously reported studies on TNT degradation on the related genera.
CONFLICT OF INTERESTS
Declared None
ACKNOWLEDGEMENT
We are greatly indebted to Thiruvalluvar University for the constant encouragement, help and support for extending necessary facilities.
REFERENCES